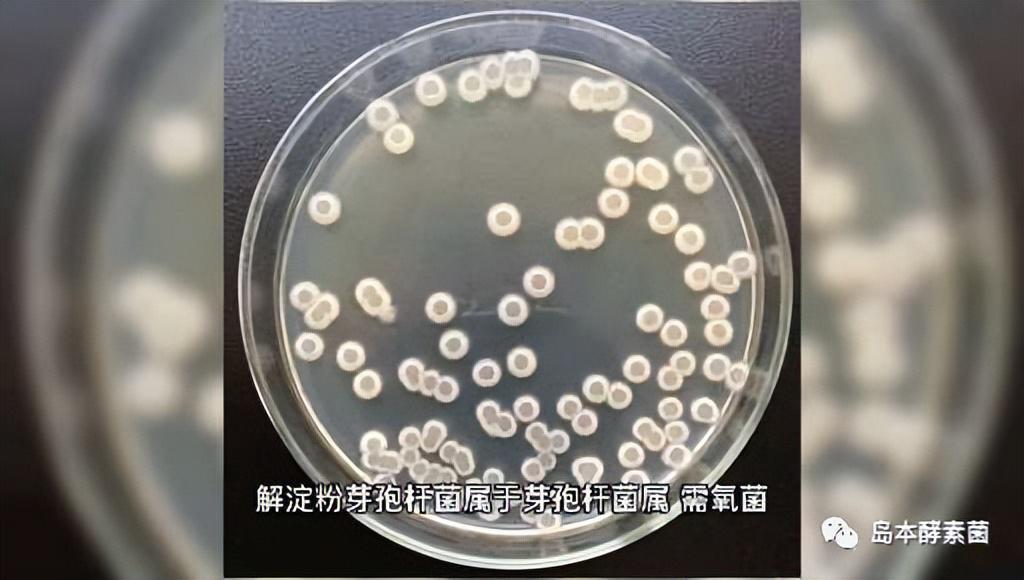

酵素菌技术防番茄自毒项目|生物技术缓解番茄青枯、根腐、病毒病
来源: 发布时间:2022-11-21 返回列表
一、酵素菌技术防番茄自毒项目立项背景
番茄在我国栽培范围广,种植面积大,在我国蔬菜生产中占有重要地位。但是,长期的连作导致作物土传病害加重,严重影响了作物的产量和品质。
潍坊岛本微生物技术研究所经调查发现:
在同一地块儿连续种植6-8年的番茄,在肥水充足的情况下,收获6~8穗果后植株即衰老死亡。
黄瓜、西葫芦、草莓5年连作的产量只相当于新地块儿的60%~80%。辣椒、茄子、西瓜、荷兰豆等也均表现出类似情况。

这是为什么呢?
对此,研究所对连作4-6年的番茄大棚进行成分测定及分析研究得出,这是由于连作后番茄根系分泌的化感物质导致。
其中主要包括苯甲酸、苯丙烯酸等自毒物质,不仅对邻近植物生长造成一定的影响,而且也影响土壤的理化性质,进而影响植保对养分的吸收和其生长发育状况。

二、酵素菌技术防番茄自毒生产生物有机肥
研究所针对番茄自毒课题进行深入调查、技术研发,先掌握微生物对自毒成分的转化分解。
然后在此基础上利用酵素菌群筛选能降解自毒物质的微生物菌群和物质,形成特定的抗番茄自毒功能菌。
除了能降解自毒物质的功能菌外,加入抑制有害菌,溶解矿质营养成分,促进生长代谢产物的其它功能菌形成具有互作的新功能菌群。
对筛选功能菌生产工艺进行优化,开发出自毒物质降解的生产生物有机肥的专用配方和生产工艺技术。

研制开发出了适合番茄不同栽培要求的系列生物有机肥,做到了生物技术和设备的配套,实现了生物有机肥的产业化开发。
最后根据地域和作物生长习性,酵素菌生物有机肥为主,复配矿质营养、保水剂、土壤改良剂等形成一套系统的作物栽培解决方案,从根本上解决土传病害问题。
此项科技成果经第三方评价达国内领先水平。

三、酵素菌技术缓解番茄青枯、根腐、病毒的效果
该成果完成实施后,合作单位建立了年产 1 万吨的微生物菌种厂,配套建设了年产 10 万吨生物有机肥厂,实现了对规模化生物质的综合性无害化处理。
成果生产相关有机肥料已在山东、辽宁、山东、河北、云南、山西、云南等地试验,取得了良好效果。

在潍坊昌乐县营丘镇进行的3年以上番茄连作改良试验中,通过对比不同肥料试验处理的效果得出,相比普通有机肥和畜禽粪肥,酵素菌技术生产的防番茄自毒生物有机肥对番茄产量、植物学性状及病毒病、枯萎病、根接线虫等土传病害各指标均有明显优势,具体指标如下表:



*注:棚1、棚2、棚3分别种植番茄为5年龄、6年龄、4年龄,处理1为本项目研制有机肥、处理2为灭菌有机肥、处理3为市售有机肥、处理4为干鸡粪配合复合肥、处理5(CK)为新型改良施肥法有机无机微生物腐殖酸肥。

该科技成果技术除了用于农业种植外,还可广泛应用于有机废弃物无害化处理,适合生产医药、化工、造纸、酿酒等产生大量有机废渣的企业的综合治理,可实现中药、肥料、种植、环境保护跨行业的协同发展,对化肥企业产业延伸及发展低碳经济和循环经济起到推动作用,具有良好的经济效益和社会效益,推广应用前景广阔。
岛本酵素:作物全程营养与生物防护!
-end-
版权声明:本文系潍坊岛本微生物技术研究所原创文章,版权所有,如需转载须注明出处!

鲁公网安备37070502000658号